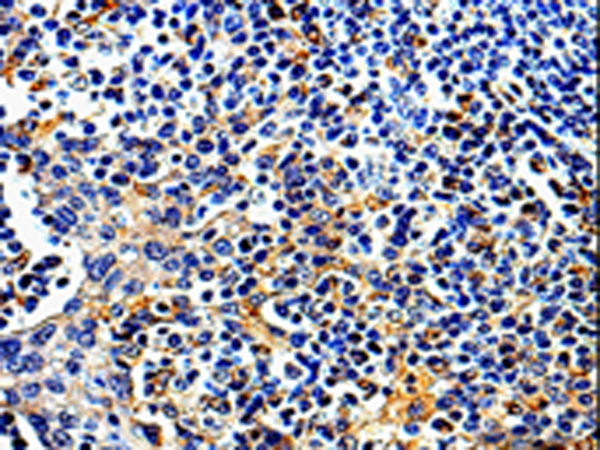

-
分类: 科研抗体货号: P07063别名: MABC1, M-ABC1, EST328128应用: WB反应种属: Human, Mouse, Rat
-
分类: 科研抗体货号: P07044别名: CRFB4, CRF2-4, D21S58, D21S66, CDW210B, IL-10R2应用: IHC反应种属: Human
-
分类: 科研抗体货号: P07019别名: APLCC应用: WB,IHC反应种属: Human, Rat
-
分类: 科研抗体货号: P07062别名: ABCB5beta; EST422562; ABCB5alpha应用: WB,IHC反应种属: Human, Mouse
-
分类: 科研抗体货号: P07043别名: CD210, IL10R, CD210a, CDW210A, HIL-10R, IL-10R1应用: IHC反应种属: Human
-
分类: 科研抗体货号: P07018别名: hCOX16; HSPC203; C14orf112应用: IHC反应种属: Human, Mouse
-
分类: 科研抗体货号: P07061别名: AARSL; COXPD8; MTALARS; MT-ALARS应用: WB,IHC反应种属: Human, Mouse, Rat
-
分类: 科研抗体货号: P07042别名: NIP1; SEC20; TRG-8应用: WB,IHC反应种属: Human, Mouse, Rat
-
分类: 科研抗体货号: P07051别名: IL18BPa应用: WB,IHC反应种属: Human
-
分类: 科研抗体货号: P07058别名: 5-HT2B, 5-HT(2B)应用: WB,IHC反应种属: Human

鄂公网安备42018502007531号
鄂公网安备42018502007531号

